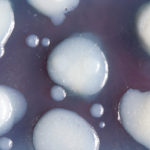
(日本語) 【10か国目、NYに来ています】

(日本語) 【10か国目、NYに来ています】
Sorry, this entry is only available in
Sorry, this entry is only available in

Sorry, this entry is only available in

Sorry, this entry is only available in

Sorry, this entry is only available in

Sorry, this entry is only available in

Sorry, this entry is only available in

Sorry, this entry is only available in

Sorry, this entry is only available in

Sorry, this entry is only available in

Sorry, this entry is only available in

Sorry, this entry is only available in

Sorry, this entry is only available in

Sorry, this entry is only available in

Sorry, this entry is only available in